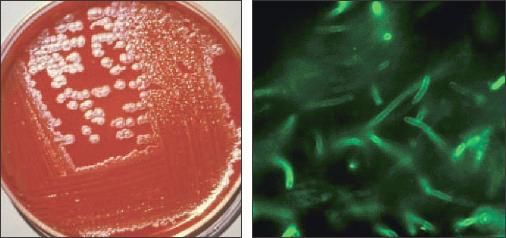

- Clinical Technology
- Adult Immunization
- Hepatology
- Pediatric Immunization
- Screening
- Psychiatry
- Allergy
- Women's Health
- Cardiology
- Pediatrics
- Dermatology
- Endocrinology
- Pain Management
- Gastroenterology
- Infectious Disease
- Obesity Medicine
- Rheumatology
- Nephrology
- Neurology
- Pulmonology
Inhalational anthrax: Recognizing the symptoms for rapid diagnosis
ABSTRACT: The 2001 anthrax attack demonstrated the UnitedStates' vulnerability to bioterrorism. Governmental and publichealth agencies are preparing for the enormous logistical challengesrequired for a response to a large-scale bioterrorist attack.These include the stockpiling and distribution of antibioticsand vaccines for prophylaxis and treatment of exposedpopulations. Given that untreated inhalational anthrax is rapidlyfatal, early identification and timely initiation of appropriatetherapy are essential. The prodromal phase of illness ischaracterized by flu-like symptoms, such as cough, fever, andfatigue, followed by respiratory distress and shock. Chest radiographicfindings include pleural effusions and widening ofthe mediastinum. (J Respir Dis. 2008;29(5):215-221)
ABSTRACT: The 2001 anthrax attack demonstrated the United States' vulnerability to bioterrorism. Governmental and public health agencies are preparing for the enormous logistical challenges required for a response to a large-scale bioterrorist attack. These include the stockpiling and distribution of antibiotics and vaccines for prophylaxis and treatment of exposed populations. Given that untreated inhalational anthrax is rapidly fatal, early identification and timely initiation of appropriate therapy are essential. The prodromal phase of illness is characterized by flu-like symptoms, such as cough, fever, and fatigue, followed by respiratory distress and shock. Chest radiographic findings include pleural effusions and widening of the mediastinum. (J Respir Dis. 2008;29(5):215-221)
The 2001 anthrax outbreak in the United States and the 1979 outbreak in Sverdlovsk, Russia, demonstrated that inhalational anthrax is no longer only of historical interest.1,2 Unfortunately, the United States is still a possible target for future bioterrorist attacks. The US Commission on National Security, headed by former Senators Rudman and Hart, concluded that the United States is vulnerable to attack and cited biological weapons, such as anthrax, as "the most likely choice and means for disaffected states and groups in the 21st century."3 There is growing evidence that Al Qaeda is attempting to "produce biological weapons, such as anthrax [to be used] on American soil."4
When untreated, inhalational anthrax results in a rapidly fatal illness- usually within 5 days of symptom onset.5 Thus, it is imperative that health care providers be aware of the clinical signs and symptoms associated with inhalational anthrax, for timely diagnosis and initiation of lifesaving therapy.
In this article, we describe the history of zoonotic, occupational, and bioterrorism-related anthrax exposures. Then, we review the clinical course of inhalational anthrax. In a coming issue of The Journal of Respiratory Diseases, we will review the guidelines for treatment.
BACKGROUND
Microbiology and pathogenesis
The aerobic, gram-positive, nonmotile, spore-forming bacterium Bacillus anthracis (size: 1 to 1.5 μm by 3 to 10 μm) causes acute infectious diseases in humans and animals (Figure 1).6 Viable anthrax spores resist environmental degradation and can exist in the soil for decades.7 Infection ensues once the spores introduced to the blood and tissue of living hosts germinate into vegetative bacilli.

Figure 1 –
Bacillus anthracis is identified here by Gram stain (A). The scanning electron micrograph reveals the spores of B anthracis (B, magnification X12,483). (Figures courtesy of the Centers for Disease Control and Prevention.)
The 3 generally accepted routes of B anthracis infection in humans are cutaneous, GI (lower or upper/pharyngeal), and inhalational.8 Although several cases of primary anthrax meningioencephalitis have been described,9 these cases are likely the result of an unrecognized lower respiratory tract10 or a transethmoidal port of entry.11-13
Inhalational anthrax is thought to occur when anthrax particles smaller than 5 μm reach the lower respiratory tract (the alveoli) where alveolar macrophages phagocytize and transport these spores to the hilar and mediastinal lymph nodes.6,14 The spores germinate and produce bacterial toxins that cause hemorrhage, edema, and necrosis.15 An initial prodromal syndrome is characterized by flu-like and respiratory symptoms, including fever, cough, and dyspnea.5,16 A poorly recognized upper airway form of inhalational anthrax, presenting with primarily nonpulmonary symptoms, also has been described.9
Inhalational anthrax is not communicable through person-to-person spread from coughing or sneezing. However, there are reported cases of human B anthracis infection spread by contaminated clothing,17 insect bites,18,19 contaminated-needle injection,20,21 and by mother-to-child transmission (intrauterine22-24 or via breast milk25).
The primary pathogenesis of B anthracis infection results from the microbe's production of protein toxins rather than from bacterial replication. This is supported by animal studies demonstrating that sterile plasma from anthrax-infected animals is lethal when injected into noninfected hosts.26
The virulence determinants of B anthracis are from the bacterial capsule and 2 exotoxins: lethal (composed of lethal factor and protective antigen) and edema toxins.6 These toxins have several intracellular effects that produce uncontrolled cytokine release, leading to septic shock and respiratory failure from pleural and pulmonary edema.15 Death is usually the result of respiratory failure or profound septic shock, which is often associated with meningioencephalitis.5
Anthrax in history
Anthrax spores primarily infect wild and domestic herbivores (such as cattle, goats, and sheep) and are endemic in sub-Saharan Africa, Asia, Eastern and Southern Europe, Central and South America, and Australia.27,28 Epidemics of human cutaneous and GI anthrax are associated with cattle herding,29-31 with early accounts of anthrax "plagues" 3500 years ago.32
Friedrich Brauell was the first to microscopically verify a human death from anthrax.33 In 1857, he observed rod-shaped, nonmotile particles in the blood of a man at autopsy; the man had died after an acute illness, and soon after he had cremated the carcasses of cows that had died of anthrax. Robert Koch was the first to culture anthrax and, in 1876, he developed his postulates for the germ theory of disease from experiments using B anthracis33-35 This work led to the development of an anthrax vaccine by Louis Pasteur in 1882.34,35
Historically, most cases of human inhalational anthrax resulted from occupational exposures to wool or animal hide.5,36 Human inhalational anthrax was first described in British textile workers exposed to the hides of sheep and goats in the mid-1800s (woolsorter's or ragpicker's disease).37,38
In the early 20th century, procedures to minimize the risk of aerosolized anthrax spore exposure were instigated in Great Britain39 and the United States,40 and the incidence of inhalational anthrax fell. In Great Britain, the number of reported human anthrax cases has declined since 1919, with a marked reduction since 1940.41,42 In the United States, the number of reported cases has declined since 1916, with a marked reduction after 1960; this decline is attributed to vaccinations (in humans and animals), improved working conditions (use of disinfectants), and decreased exposure to imported contaminated animal products.43,44
Other countries have reported similar declines in human anthrax,45-47 with the annual incidence (of all forms of anthrax) decreasing from an estimated 100,000 in the early 1900s to 2000 currently.48 Since 2001, 3 cases of inhalational anthrax presumed secondary to occupational exposure have been reported in the United States, Scotland, and India.49-51 Two of the patients made drums with untreated animal hides, and 2 patients died despite receiving antibiotic therapy.
Anthrax as a biological weapon
Any country or group that has basic microbiology expertise can produce weapons-grade anthrax with minimal expense. Between 1900 and 2001, 159 cases of inhalational anthrax were reported worldwide-more than half of these cases resulted from intentional or unintentional bioterrorism-related activities.2,5
During World War I, Germany contaminated animal feed and infected livestock with anthrax spores.7,52 During World War II, Japan's Unit 731 conducted human research using biological weapons, including anthrax, infecting approximately 10,000 prisoners of war.53,54 Also during World War II, the British army tested weaponized anthrax delivery systems on the Scottish island of Guinard.7 Anthrax spores from these tests remained viable until a massive decontamination effort was undertaken in the 1980s.
Both the United States and the former Soviet Union have tested and "weaponized" anthrax spores. However, in 1970, the United States ended the production of all biological weapons and in 1972, 140 nations including the United States signed the treaty on Bio logical and Toxin Weapons Convention, banning the production and stockpiling of biological weapons.55 However, the Soviet Union, a signatory to this convention, continued to produce and stockpile weaponized anthrax. This was demonstrated in 1979 by an unintentional release of an estimated 1-mg amount of B anthracis spores in Sverdlovsk, resulting in 77 known cases of inhalational anthrax and more than 60 deaths.2,28 Hundreds of additional unreported cases likely occurred during this outbreak.56,57
From these historical cases of anthrax bioterrorism and other experimental evidence, it is estimated that an urban aerosol release of 1 kg of weapons-grade anthrax particles would kill more than 100,000 persons and a 100-kg release would kill nearly 3 million.58,59 In comparison, anthrax is 100 to 1000 times more lethal (per weight) than the most potent chemical weapon.60
The number of countries suspected of having weaponized anthrax has doubled since 1975.61 In the 1980s, Iraq stockpiled 8500 L of concentrated anthrax spores and produced 50 aerial bombs and 10 SCUD missiles armed with anthrax.55,62 After the first Gulf War, the United Nations Special Commission on Iraq destroyed Iraq's facilities to produce and stockpile anthrax.63 In the 1990s, the Japanese cult Aum Shinrikyo unsuccessfully attempted to release anthrax spores in Tokyo, eventually resorting to sarin gas.55
In 2001, 11 persons in the United States were infected with inhalational anthrax from presumed bioterrorism-related exposure to spores disseminated via the postal system; 5 of these persons died.5,64,65 During this attack, more than 10,000 persons were offered at least 60 days of antimicrobial prophylaxis,66 with direct costs (cleanup, prophylaxis, laboratory tests, etc) estimated at more than $4 billion.67
CLINICAL PRESENTATION AND DIAGNOSIS
Asymptomatic prodrome
After the inhalation of anthrax particles, an asymptomatic incubation period ensues. The incubation period represents the time from infection (inhalation of spores) to symptom onset (spore germination and toxin production).
In studies of untreated animals, incubation periods as long as 98 days have been demonstrated.68 Among untreated humans, the incubation period can be as short as 2 days, with a median duration of 10 to 14 days.56,57 Of the 6 US cases for which the time of exposure is known, the incubation period ranged from 4 to 7 days.64
The widespread use of prophylactic strategies for potentially exposed persons during the 2001 attack likely reduced subsequent cases of inhalational anthrax.69-72 During the 1979 Sverdlovsk outbreak, no cases of human anthrax were reported after 60 days of exposure.2,56 However, widespread use of antibiotic prophylaxis and anthrax vaccine probably reduced the incubation period.56
Symptomatic phases
Symptoms occur after anthrax spores germinate and produce toxins. The symptomatic clinical course of untreated inhalational anthrax is biphasic, with an initial prodromal latent phase characterized by flu-like symptoms (cough, fever, and fatigue), followed by a severe fulminant acute phase characterized by respiratory distress and shock that usually culminates in death.5,36,73,74 If untreated, the prodromal phase lasts approximately 4 days, and the fulminate phase lasts about 24 hours.5
Four reviews have described the classic signs and symptoms of inhalational anthrax (Table).5,16,75,76 The most common symptoms at presentation include chills or fever (67%), malaise (64%), cough (62%), and dyspnea (52%). Most patients at presentation were febrile (66%) or tachycardic (66%). Of the 26 patients who had a chest radiograph, all had abnormalities, including pleural effusions (69%) and widened mediastinum (54%) (Figure 2). However, because chest radiographs were obtained from only 32% of all reported cases of inhalational anthrax, the lack of a radiographic abnormality should not exclude the diagnosis.5

Figure 2 – These chest radiographs are from a 49-year-old postal worker who had untreated inhalational anthrax. He presented to an emergency department complaining of myalgia, fatigue, nausea, stomach pain, and light-headedness of 3 days' duration. A chest radiograph showed a right suprahilar density (A). Unfortunately, the patient was sent home without antibiotics, but returned 24 hours later complaining of syncope, diaphoresis, and ongoing GI complaints. His chest radiograph showed increasing perihilar/infrahilar densities (B). He was triaged inappropriately and within 3 hours had septic shock complicated by hypoxemic, hypercapnic respiratory failure requiring mechanical ventilation. His radiograph showed a new right upper lobe infiltrate (C). Despite antibiotics, refractory septic shock and worsening respiratory failure developed, with radiographic evidence of increasing right upper lobe infiltrate and new bilateral pleural effusions (D). The patient died 4 hours later.

CT findings that are highly suggestive of inhalational anthrax include mediastinal or hilar lymph node enhancement with hypodense centers (necrosis/hemorrhage) associated with mediastinal edema and pleural or pericardial effusions.77,78 However, a delayed follow-up CT scan may be needed to detect lymph node enhancement.77 The CDC recommends a CT scan when inhalational anthrax is suspected and the chest radiographic findings are normal.79
Because the early symptoms of inhalational anthrax resemble those of influenza or influenza-like illness, it is essential that clinicians have a high degree of suspicion of anthrax to make timely diagnosis and institute lifesaving therapy. Despite widespread media coverage during the 2001 attack, 4 symptomatic postal workers who initially sought medical attention were sent home with the diagnosis of viral illness, 2 with oral antibiotics and 2 without therapy.64 The 2 not given antibiotics died within 24 to 72 hours after initial presentation.80 Unfortunately, even after this experience, the ability of health care providers to diagnose inhalational anthrax is still poor.81,82
Clinicians should entertain the diagnosis of anthrax in patients with flu-like symptoms that do not coincide with the influenza season or when patients with such symptoms have a common environmental association, such as attendance at the same concert or arena, or common occupational exposure (postal workers).
Diagnostic confirmation
The gold standard for identifying and confirming anthrax is by microscopic examination of stained smears of body fluid and tissue, colony morphology on blood agar, the M'Fadyean reaction, and motility test.83 In vitro, anthrax grows optimally on blood agar plates at a temperature of 35°C (95°F), usually within 24 hours (Figure 3).
Figure 3 –
Bacillus anthracis is shown here on agar culture (left) and by direct fluorescent antibody stain of the cell wall (right, magnification X1000). (Figures courtesy of the Centers for Disease Control and Prevention.)
However, anthrax bacilli must be differentiated from other Bacillus species (especially Bacillus cereus) by specialized methods, such as animal inoculation (mice or guinea pig) or polymerase chain reaction amplification of toxin and capsule genes.6,83 These techniques take time (days to weeks). Immunohistochemical methods (such as enzymelinked immunosorbent assay) using monoclonal antibodies against the cell wall and capsule have been developed to more rapidly and accurately diagnose anthrax infection.83-86 However, because these techniques are not widely available, clinicians should consider anthrax and initiate treatment when cultures (from any source) contain gram-positive bacilli while they are awaiting confirmatory diagnostic results.
[Editor's note: In a coming issue of The Journal of Respiratory Diseases, the authors will focus on strategies for prophylaxis and treatment of inhalational anthrax.]
References:
REFERENCES
1.
Jernigan DB, Raghunathan PL, Bell BP, et al. Investigation of bioterrorism-related anthrax, United States, 2001: epidemiologic findings.
Emerg Infect Dis.
2002;8:1019-1028.
2.
Meselson M, Guillemin J, Hugh-Jones M, et al. The Sverdlovsk anthrax outbreak of 1979.
Science.
1994;266:1202-1208.
3.
US Commission on National Security/21st Century, Hart-Rudman Task Force on Homeland Security.
New World Coming: American Security in the 21st Century.
http://www.fas.org/man/docs/nwc
. Published September 1999. Accessed April 8, 2008.
4.
Department of Defense. Verbatim transcript from: Combatant Status Review Tribunal Hearing for ISN 10024-Khalid Shaykh Muhammad.
http://www.defenselink.mil/news/ISN10024.pdf
. Accessed December 5, 2007.
5.
Holty JE, Bravata DM, Liu H, et al. Systematic review: a century of inhalational anthrax cases from 1900 to 2005.
Ann Intern Med.
2006;144:270-280.
6.
Inglesby TV, O'Toole T, Henderson DA, et al. Anthrax as a biological weapon, 2002: updated recommendations for management.
JAMA.
2002;287:2236-2252.
7.
Christopher GW, Cieslak TJ, Pavlin JA, Eitzen EM Jr. Biological warfare. A historical perspective.
JAMA.
1997;278:412-417.
8.
Friedlander AM. Anthrax. In: Zajtchuk R, Bellamy RF, eds.
Textbook of Military Medicine: Medical Aspects of Chemical and Biological Warfare.
Washington, DC: Office of the Surgeon General, Dept of the Army; 1997:467-478.
9.
Holty JE, Kim RY, Bravata DM. Anthrax: a systematic review of atypical presentations.
Ann Emerg Med.
2006;48:200-211.
10.
Al-Allaf GA. Anthrax meningitis.
Trans R Soc Trop Med Hyg.
1978;72:315.
11.
Croix IC, Pluot M. Un cas de charbon humain à localisation unique cérébroméningée, observé dans la région de Reims.
Med Mal Infect.
1975;5:229-230.
12.
Pluot M, Vital C, Aubertin J, et al. Anthrax meningitis. Report of two cases with autopsies.
Acta Neuropathol.
1976;36:339-345.
13.
Mitchell GF. Meningeal anthrax.
Br Med J.
1921;2:508.
14.
Druett HA, Henderson DW, Packman L, Peacock S. Studies on respiratory infection. I. The influence of particle size on respiratory infection with anthrax spores.
J Hyg (Lond).
1953;51:359-371.
15.
Sherer K, Li Y, Cui X, Eichacker PQ. Lethal and edema toxins in the pathogenesis of Bacillus anthracis septic shock: implications for therapy.
Am J Respir Crit Care Med.
2007;175:211-221.
16.
Hupert N, Bearman GM, Mushlin AI, Callahan MA. Accuracy of screening for inhalational anthrax after a bioterrorist attack.
Ann Intern Med.
2003;139:337-345.
17.
The conveyance of the anthrax bacillus in clothes.
JAMA.
1913;60:1311.
18.
Williamson GA. The Cyprus sphalangi and its connection with anthrax.
Br Med J.
1900:558-561.
19.
Ménétrier M, Clunet M. A fatal case of anthrax (charbon).
Lancet.
1907;1:394.
20.
Ringertz SH, Høiby EA, Jensenius M, et al. Injectional anthrax in a heroin skin-popper.
Lancet.
2000;356:1574-1575.
21.
Lalitha MK, Anandi V, Walter NM, et al. Primary anthrax presenting as an injection abscess.
Indian J Pathol Microbiol.
1988;31:254-256.
22.
Regan JC, Litvak A, Regan C. Intra-uterine transmission of anthrax.
JAMA.
1923;80:1769-1771.
23.
Sujatha S, Parija SC, Bhattacharya S, Devi CS, et al. Anthrax peritonitis.
Trop Doct.
2002;32:247-248.
24.
Handjani AM, Salimi F, Daneshbod K. Case A-161-74 (Saadi Hospital): clinical pathological exercise. Intestinal anthrax.
Pahlavi Med J.
1976;7:147-159.
25.
Vogt E. Ueber die beziehungen der milzbrandsepsis und laktation.
Berl Klin Wschr.
1919;56:703-704.
26.
Smith H, Keppie J. Observations on experimental anthrax: demonstration of a specific lethal factor produced in vivo by Bacillus anthracis.
Nature.
1954;173:869-870.
27.
Turnbull PCB.
Guidelines for the Surveillance and Control of Anthrax in Human and Animals.
3rd ed. World Health Organization, Emerging and other Communicable Diseases, Surveillance and Control; 1998.
http://www.who.int/csr/resources/publications/anthrax/whoemczdi986text.pdf
. WHO/EMC/ZDI/98.6.
28.
Guillemin J.
Anthrax: The Investigation of a Deadly Outbreak.
Berkeley, CA: University of California Press; 1999.
29.
Davies JC. A major epidemic of anthrax in Zimbabwe.
Cent Afr J Med.
1982;28(1, pt 3):291-298.
30.
Davies JC. A major epidemic of anthrax in Zimbabwe.
Cent Afr J Med.
1983;29(2, pt 3):8-12.
31.
Davies JC. A major epidemic of anthrax in Zimbabwe. The experience at the Beatrice Road Infectious Diseases Hospital, Harare.
Cent Afr J Med.
1985;31(3, pt 3):176-180.
32.
Shafazand S, Doyle R, Ruoss S, et al. Inhalational anthrax: epidemiology, diagnosis, and management.
Chest.
1999;116:1369-1376.
33.
Swiderski RM.
Anthrax: A History.
Jefferson, NC: McFarland & Company; 2004.
34.
Zydowicz D. Anthrax: a disease from antiquity visits the modern world.
Minn Med.
1998;81:19-20.
35.
Weiss R. Robert Koch: the grandfather of cloning?
Cell.
2005;123:539-542.
36.
Brachman PS. Inhalation anthrax.
Ann N Y Acad Sci.
1980;353:83-93.
37.
Eurich FW. The history of anthrax in the wool industry of Bradford and of its control.
Lancet.
1926;i:57-58.
38.
LaForce FM. Woolsorters' disease in England.
Bull N Y Acad Med.
1978;54:956-963.
39.
Eurich FW. The cultivation of anthrax bacilli from wool and hair.
J Pathol Bacteriol.
1912;17:249-253.
40.
Smyth HF. Anthrax-a continuing and probably increasing hazard of industry.
Am J Public Health.
1924;14:920-924.
41.
Ministry of Labour. Report of the Committee of Inquiry on Anthrax. London: HMSO; 1959.
42.
Epidemiology: Anthrax.
Br Med J.
1971;2:598.
43.
Wolff A, Heimann H. Industrial anthrax in the United States, an epidemiologic study.
Am J Hyg.
1951;53:80-109.
44.
Brachman PS. Anthrax.
Ann N Y Acad Sci.
1970;174:577-582.
45.
Moya V, Valdivieso A. Estado actual del carbunco en las Americas.
Bol Oficina Sanit Panam.
1963;55:84-96.
46.
Schmid G, Kaufmann A. Anthrax in Europe: its epidemiology, clinical characteristics, and role in bioterrorism.
Clin Microbiol Infect.
2002;8:479-488.
47.
Parvizpour D. Human anthrax in Iran: an epidemiological study of 486 cases.
Intl J Zoonoses.
1978;5:69-74.
48.
Brachman PS. Bioterrorism: an update with a focus on anthrax.
Am J Epidemiol.
2002;155:981-987.
49.
Walsh JJ, Pesik N, Quinn CP, et al. A case of naturally acquired inhalation anthrax: clinical care and analyses of anti-protective antigen immunoglobulin G and lethal factor.
Clin Infect Dis.
2007;44:968-971.
50.
Eurosurveillance editorial team. Probable human anthrax death in Scotland.
Euro Surveillance: Bulletin Européen sur les Maladies Transmissibles: European Communicable Disease Bulletin.
2006;11:E060817.2.
51.
Velayudhan MN, Nalini P, Kanungo R, et al. Inhalational anthrax with acute respiratory distress syndrome.
Ann Trop Paediatr.
2005;25:49-52.
52.
Committee on Research Standards and Practices to Prevent the Destructive Application of Biotechnology, National Research Council.
Biotechnology Research in an Age of Terrorism.
Washington, DC: National Academies Press; 2004.
53.
Harris SH.
Factories of Death: Japanese Biological Warfare, 1932-45, and the American Coverup.
New York: Routledge; 1994.
54.
Williams P, Wallace D.
Unit 731: Japan's Secret Biological Warfare in World War II.
New York: Free Press; 1989.
55.
Kadlec RP, Zelicoff AP, Vrtis AM. Biological weapons control. Prospects and implications for the future.
JAMA.
1997;278:351-356.
56.
DA. The statistical analysis of truncated data: application to the Sverdlovsk anthrax outbreak.
Biostatistics.
2001;2:233-247.
57.
Wilkening DA. Sverdlovsk revisited: modeling human inhalation anthrax.
Proc Natl Acad Sci U S A.
2006;103:7589-7594.
58.
Wein LM, Craft DL, Kaplan EH. Emergency response to an anthrax attack.
Proc Natl Acad Sci U S A.
2003;100:4346-4351.
59.
Office of Technology Assessment, U.S. Congress.
Proliferation of Weapons of Mass Destruction.
Washington, DC: US Government Printing Office; 1993:53-55. Publication OTA-ISC-559.
60.
Guillemin J.
Biological Weapons: From the Invention of State-Sponsored Programs to Contemporary Bioterrorism.
New York: Columbia University Press; 2005.
61.
Holum JD.
Remarks for the Fourth Review Conference of the Biological Weapons Convention.
Geneva: US Arms Control and Disarmament Agency; 1996.
62.
Bossi P, Tegnell A, Baka A, et al. Bichat guidelines for the clinical management of anthrax and bioterrorism-related anthrax.
Euro Surveill.
2004;9:e3-e4.
63.
Zilinskas RA. Iraq's biological weapons. The past as future?
JAMA.
1997;278:418-424.
64.
Jernigan JA, Stephens DS, Ashford DA, et al. Bioterrorism-related inhalational anthrax: the first 10 cases reported in the United States.
Emerg Infect Dis.
2001;7:933-944.
65.
Barakat LA, Quentzel HL, Jernigan JA, et al. Fatal inhalational anthrax in a 94-year-old Connecticut woman.
JAMA.
2002;287:863-868.
66.
Centers for Disease Control and Prevention. Update: investigation of bioterrorism-related anthrax, 2001.
MMWR.
2001;50:1008-1010.
67.
Cole LA. The anthrax attacks. Presented at: Conference on Information in BioDefense and Counter-Terrorism; May 12, 2004; Rutgers University-Newark, NJ.
http://informatics.umdnj.edu/institute/events/IAIMS0405/Cole.pdf
. Accessed January 22, 2008.
68.
Glassman HN. Discussion.
Bacteriol Rev.
1966;30:657-659.
69.
Jefferds MD, Laserson K, Fry AM, et al. Adherence to antimicrobial inhalational anthrax prophylaxis among postal workers, Washington, DC, 2001.
Emerg Infect Dis.
2002;8:1138-1144.
70.
Baggett HC, Rhodes JC, Fridkin SK, et al. No evidence of a mild form of inhalational Bacillus anthracis infection during a bioterrorism-related inhalational anthrax outbreak in Washington, DC, in 2001.
Clin Infect Dis.
2005;41:991-997.
71.
Brookmeyer R, Blades N. Prevention of inhalational anthrax in the U.S. outbreak.
Science.
2002;295:1861.
72.
Doolan DL, Freilich DA, Brice GT, et al. The US capitol bioterrorism anthrax exposures: clinical epidemiological and immunological characteristics.
J Infect Dis.
2007;195:174-184.
73.
Brachman PS, Kaufmann AF. Anthrax. In: Evans AS, Brachman PS, eds.
Bacterial Infections of Humans: Epidemiology and Control.
3rd ed. New York: Plenum Medical Book Company; 1998:23:6.
74.
Friedlander AM. Anthrax: clinical features, pathogenesis, and potential biological warfare threat.
Curr Clin Top Infect Dis.
2000;20:335-349.
75.
Kuehnert MJ, Doyle TJ, Hill HA, et al. Clinical features that discriminate inhalational anthrax from other acute respiratory illnesses.
Clin Infect Dis.
2003;36:328-336.
76.
Kyriacou DN, Stein AC, Yarnold PR, et al. Clinical predictors of bioterrorism-related inhalational anthrax.
Lancet.
2004;364:449-452.
77.
Krol CM, Uszynski M, Dillon EH, et al. Dynamic CT features of inhalational anthrax infection.
AJR.
2002;178:1063-1066.
78.
Wood BJ, DeFranco B, Ripple M, et al. Inhalational anthrax: radiologic and pathologic findings in two cases.
AJR.
2003;181:1071-1078.
79.
Centers for Disease Control and Prevention. Update: investigation of bioterrorism-related anthrax and interim guidelines for clinical evaluation of persons with possible anthrax [published correction appears in
MMWR.
2001;50:991].
MMWR.
2001;50:941-948.
80.
Borio L, Frank D, Mani V, et al. Death due to bioterrorism-related inhalational anthrax: report of 2 patients.
JAMA.
2001;286:2554-2559.
81.
Cosgrove SE, Perl TM, Song X, Sisson SD. Ability of physicians to diagnose and manage illness due to category A bioterrorism agents.
Arch Intern Med.
2005;165:2002-2006.
82.
Leiba A, Goldberg A, Hourvitz A, et al. Lessons learned from clinical anthrax drills: evaluation of knowledge and preparedness for a bioterrorist threat in Israeli emergency departments.
Ann Emerg Med.
2006;48:194-199.
83.
Guarner J, Jernigan JA, Shieh WJ, et al. Pathology and pathogenesis of bioterrorism-related inhalational anthrax.
Am J Pathol.
2003;163:701-709.
84.
Sastry KS, Tuteja U, Santhosh PK, et al. Identification of Bacillus anthracis by a simple protective antigen-specific mAb dot-ELISA.
J Med Microbiol.
2003;52(pt 1):47-49.
85.
Quinn CP, Semenova VA, Elie CM, et al. Specific, sensitive, and quantitative enzyme-linked immunosorbent assay for human immunoglobulin G antibodies to anthrax toxin protective antigen.
Emerg Infect Dis.
2002;8:1103-1110.
86.
Brachman PS, Gold H, Plotkin SA, et al. Field evaluation of a human anthrax vaccine.
Am J Public Health.
1962;52:632-645.
